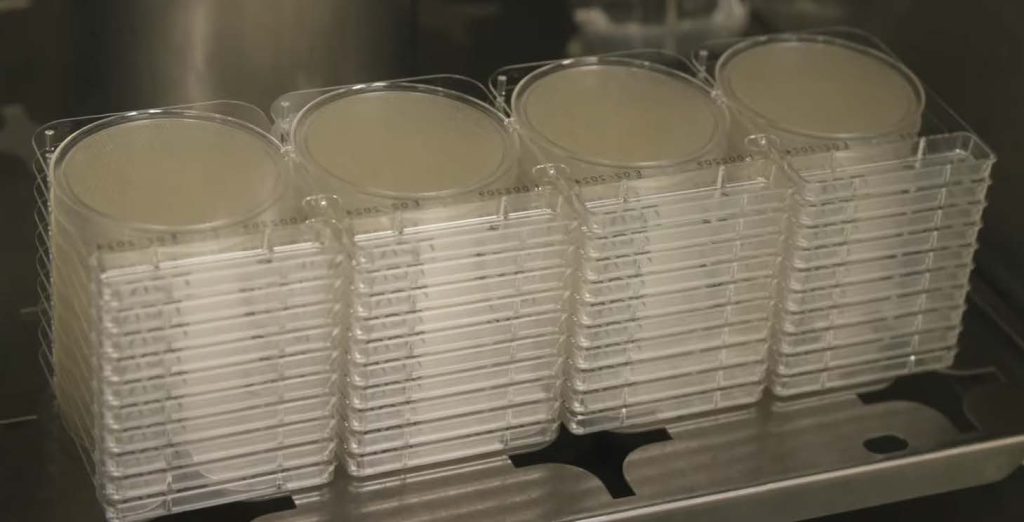
Clean cut clones, settle plates

Cloning Cannabis at Scale: Why Success Rate Matters More Than Volume
After mother plants, cloning is the most leveraged process in commercial cannabis cultivation. Every plant cutting represents investment in future canopy, labor, square footage, and time. Too often, cloning rooms are treated like a numbers game: take thousands of cuts, expect losses, and compensate by taking more next week. That mindset quietly erodes margins and significantly increases risk.
Elite cultivation teams focus on their cutting success rates rather than the raw output. A 98% clone strike rate is cleaner, AND it is cheaper, faster, and dramatically safer than producing excess clones to offset avoidable failures. The difference almost always comes from disciplined sanitation and respect for the biology of stressed plant tissue.
Every Clone Is a Wound—and a Test
Clones are not seedlings. They are amputated plant tissue relying entirely on stored energy and environmental conditions to survive long enough to form roots. When a cutting is taken, it becomes a stress response event, an open vascular system, and a high-risk pathogen entry point all at once.
This is why clone success rates are often the earliest indicator of deeper facility issues. When cuttings stall, yellow, dampen off, or root unevenly, the problem is rarely genetics. More often, it is contamination, tool hygiene, or environmental inconsistency introduced during the cloning process. Because cloning is repetitive and high-volume, small lapses compound rapidly.

High Success Rates Still Start with Healthy Mothers
Cloning success is largely determined before the first cut is taken. Mother plants require a level of care distinct from production plants. They live longer, are wounded repeatedly, and must maintain continuous vegetative growth without decline.
Nutrient imbalance, chronic pathogen pressure, viral load, or subtle stress may not immediately appear in a mother plant, but those weaknesses will appear quickly in her clones. Slow callusing, uneven rooting, and post-transplant stalling are all downstream consequences of compromised source material.
No cloning protocol can compensate for unhealthy mothers. In practice, we see that clone rooms amplify the condition of the mother – whether good or bad. Strong mothers produce cuttings that root faster, transition more smoothly, and require fewer corrective inputs later in the cycle.

Sanitation Is the Primary Driver of Clone Success
Because cloning involves constant cutting, dipping, handling, and high humidity, sanitation should not be a supporting task—it is the core process of a successful commercial cannabis IPM strategy. Most clone failures stem from mechanical transmission of pathogens on tools, hands, gloves, and benches, or from biofilms that persist in trays, domes, and irrigation components. These are preventable with proper protocols.
Every cut must be treated as a sterile procedure:
- Dip tools in a broad-spectrum disinfectant between every plant, not between batches.
- Wipe benches, trays, domes, and work surfaces daily with a no-rinse disinfectant.
- Treat floors and drains as reservoirs that allow pathogens to migrate upward – disinfect regularly.
ProKure V handles this sanitation protocol efficiently.
For deeper protection, periodic room-level decontamination with ProKure G chlorine dioxide gas is beneficial for the airspace and hidden surfaces that wipes cannot reach—an especially important safeguard in warm, humid clone environments where pathogens thrive.

Why “Just Take More Cuttings” Is a Costly Myth
It is common to hear that clones are cheap, and losses are acceptable because volume makes up the difference. The truth is that low success rates create cascading costs that are easy to underestimate:
- Increased labor to take, label, track, and cull excess cuttings
- Wasted rooting media, hormones, trays, and bench space
- Uneven transplant timing that disrupts veg and flower schedules
- Elevated pathogen pressure from decaying plant material
- A false sense of security that masks systemic contamination
Taking more cuttings does not solve the problem—it normalizes failure and hides underlying risks. Facilities that consistently achieve high strike rates can operate smaller clone rooms, turn benches faster, transplant more uniformly, and detect contamination earlier. High success rates are a marker of operational maturity, not luck.

Environmental Precision Supports Sanitation
Clone environments must be precise because stressed tissue has no defenses. Temperature, humidity, VPD, and airflow must work together to support callusing while preventing microbial growth. High humidity without sanitation and airflow creates ideal conditions for Botrytis, Pythium, and bacterial rot, while excessive airflow or low humidity desiccates cuttings before roots can form.
Clean air, clean surfaces, and stable environmental parameters form a unified system. When one element is neglected, the others are forced to compensate—and failures follow.

Monitor the Clone Room Like a Production Space
Clone rooms are often excluded from routine testing, yet they represent one of the highest-risk stages of the entire cultivation cycle. Your cannabis IPM program must include airborne spore sampling, surface swabs, settle plates, and periodic PCR testing of tissue culture for pathogens such as Aspergillus, HLVd, and root diseases to provide a warning long before problems appear in flower.
Tracking trends over time is more valuable than rudimentary pass/fail results. Consistent reports provide perspective that supports informed decisions. Rising counts signal the need for immediate intervention, allowing growers to act before losses escalate.
Cloning Is Not a Side Task—It’s the Start of the Cycle
Every production run begins in the clone room. Errors made here echo forward for months, affecting yield, uniformity, and labor efficiency. Strong clone success rates are not achieved by rushing, cutting corners, or compensating with volume. They are engineered through healthy mothers, obsessive sanitation, disciplined handling, environmental precision, and consistent monitoring.
If mother plants are the genetic vault, then the clone room is the security checkpoint. Treat it casually, and contamination saunters into your facility unchecked. The most profitable cultivators do not simply hope their clones root well; these cultivators design systems that engineer success.
